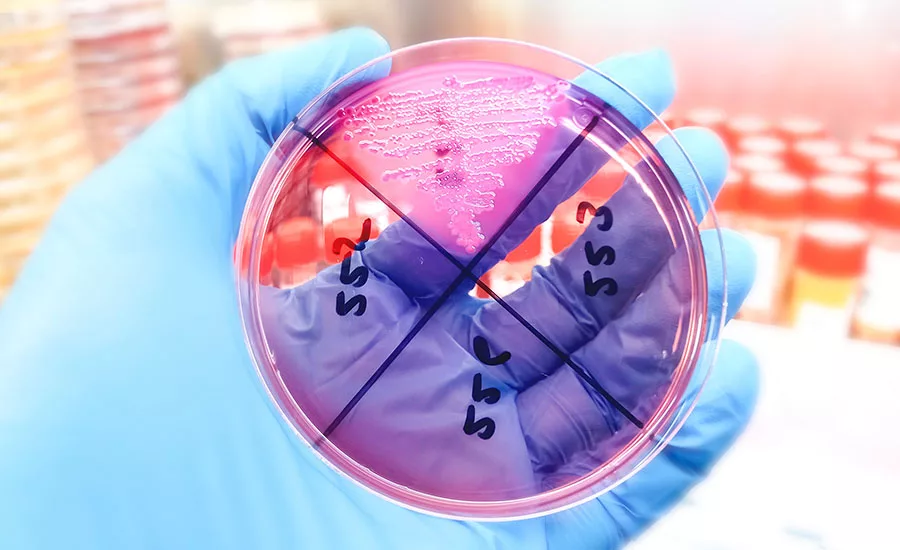
The image shows a microscopic view of a cell, likely a type of white blood cell, possibly a neutrophil, with a multi-lobed nucleus and granular cytoplasm.
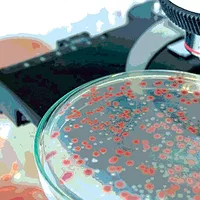

A Look at the Growth of the Global Food Safety and Beverage Microbiology Testing Market
Food safety microbiology is fundamental to any food safety program, but it also plays a role in the dynamic global marketplace
In the August/September Food Safety Insights column,1 I discussed some of the trends that we are likely to see in the coming years based on the surveys and interviews we have conducted over the past few years. In this column, we will take a look at what is currently happening in the specific area of microbiology analytical testing. I will also make a few forecasts about the future growth of this market.
Food safety microbiology is, of course, fundamental to any food safety program, but it also plays a role in the dynamic global marketplace. In 2025, the market for microbiological tests and materials used in food and beverage production includes more than 2 billion analytical tests annually, with a market value in excess of $6.6 billion dollars.
Since 1999, Strategic Consulting Inc. has periodically published its Industrial Microbiology Markets Report series to describe and characterize the global markets for microbiology analysis. In August of this year, we published our sixth edition of this series of reports—"Industrial Microbiology Markets Report, 6th Edition" (i.e., IMMR-6). This report, like its predecessors, profiles the microbiology testing markets in six distinct market areas, including the food and beverage quality testing markets. It also covers other major markets including testing in pharmaceuticals, cosmetics/personal products, water/wastewater, and industrial applications. This article focuses on some of the details of the food and beverage testing markets.
Food Safety Microbiology: Market Overview
The food safety sector is built on tens of thousands of major, global processing plants that each collect an average of 41,000 microbiology tests annually. The sizes of these facilities vary widely, with test volumes ranging from less than 100 per month to more than several hundred tests each day. They represent the largest segment of the industrial microbiology market, accounting for nearly 2 billion analytical tests, with a market value approaching US$6 billion. Due to the sizes and scope of some types of facilities, two processing verticals within this market—protein and packaged foods—account for two-thirds of the total test volume, underscoring the intensity of test volumes in higher-risk food categories and the overall size of these categories.
Market Growth Trends and Drivers
From 2018–2025, microbiology testing in food safety saw increases in market value and test volumes in the range of 5–6 percent as a compound annual growth rate (CAGR). The market showed steady growth, despite the dramatic, global disruptions of the COVID-19 pandemic; consolidation in the customer base caused by outsourcing of analysis to commercial laboratories; and the continued shift from traditional growth methods to molecular, immunoassay, and automated test methods. As I mentioned in the August/September column,1 we expect to see the rate of commercial laboratory outsourcing growth slow as the laboratory markets in North America and Europe reach saturation.
The transition in test methods will continue, especially in the global regions outside of North America and Europe. The market forecast through 2029 shows a modestly increased rate of test volume growth and an increase in market value growth of approximately 1 percentage point or more from current rates, driven mainly by this shift to higher-priced, instrument-based, and automation analytical methods. This expected shift will occur predominately in developing world regions outside of the mature, saturated markets in North America and Europe. We forecast that this growth may empower some competitive diagnostic test and laboratory material companies to increase test prices. Many companies have been experiencing price erosion in certain market segments in recent years.
Average Cost Per Test
Much to the benefit of the buyers of microbiological tests, the average cost per test (ACT) has been flat or shown only modest increases in recent years. One of the two major drivers of ACT in this market is the test formats being used. ACT increases when test buyers switch from relatively low-priced growth-based tests to higher-priced rapid and instrument-based (e.g., molecular, immunoassay, automated) test formats. This format conversion has been occurring around the world for more than a decade and has an impact on ACT and market value.
Looking for quick answers on food safety topics?
Try Ask FSM, our new smart AI search tool.
Ask FSM →
The other driver of ACT—basic price increases for the same tests—has been muted in recent years, partially due to a high level of competition in many of the developed world markets. Some particularly competitive sectors have seen significant price erosion, driven by competition for supply contacts with large laboratory networks and large food company customers (e.g., protein production and certain segments of processed foods). All these buyers have scale in their favor, with accompanying pricing power. This impact is apparent in the ACT in the instrument-based molecular and immunoassay pathogen test formats. These pricing dynamics will largely continue through the end of the decade, with ACT growing somewhat faster than test volume growth.
Organism and Methodology Trends
In what should be no surprise to any reader of Food Safety Insights, analysis for indicator organisms (e.g., TVO, coliforms/E. coli, yeast/mold) account for roughly three-quarters of microbiology test volume in food safety. These tests are used in many applications, but primarily for environmental monitoring (EM). These indicator organism tests are rounded out with ATP-based hygiene testing, a category that has recently seen somewhat above-average market growth.
In pathogen testing, Listeria and Salmonella remain the top targets and represent the majority of pathogen analyses. Listeria test volume has been the fastest growing in the pathogen category, and analysis for Listeria species (rather than for L. monocytogenes) is the largest proportion of the tests. These types of tests have shown stronger-than-average market growth due to regulatory and contamination risk focuses.
Outsourcing and Market Consolidation
The rapid growth of commercial microbiology laboratories has been driven by the outsourcing trend over the past decade that has fundamentally changed the food safety testing analytical market. Commercial laboratories now analyze an estimated 60–70 percent (or more, in some sectors) of pathogen analyses in North America and Europe, driving both volume and price competition. Large, commercial lab networks now comprise a large percentage of the customer base for diagnostic test kit suppliers. The scale of these entities exerts downward pressure on prices, even with growing test volumes.
However, the growth in the laboratory market is slowing as outsourcing reaches saturation, especially in North America and Europe. With fewer new food companies left to convert to outsourcing and modest overall sample volume growth, the commercial laboratory market is becoming more competitive, and growth is sought through competitive conversions and competition for market share. This makes the lab market more price-competitive, as well. To defend their margins, laboratories are using their leverage to secure further price concessions from their suppliers, driving even greater price pressure on test and material suppliers. Laboratories are also consolidating through acquisition, further increasing their scale.
Complacency and Risk-Based Testing
As we mentioned in the August/September column,1 as many food processors accumulate data showing "passing" EM tests, many have indicated that they are considering reducing, or have already reduced, their EM test volumes. As we mentioned in the previous Food Safety Insights column, our surveys from only five years ago showed that food processors in the U.S., Canada, and Europe that said they would be increasing their EM test volumes outnumbered those planning reductions by a ratio of 20:1 in the U.S./Canada and 15:1 in Europe. In recent surveys, this ratio has dropped to less than 5:1 in the U.S./Canada and less than 2:1 in Europe. This balance still tilts toward an increasing rate of organic growth, but at a far slower rate, contributing to our forecasts for modest test volume growth.
Beverage Sector: Market Overview
The beverage sector is characterized by stability and consolidation. Major multinational producers (e.g., Coca-Cola, PepsiCo, InBev) dominate global production through hundreds of large facilities, while a burgeoning community of smaller bottlers represent a larger volume of smaller facilities and include craft breweries, wineries, and innovative beverage startups.
The overall market for beverage producers is facing significant challenges as rapidly changing consumer tastes alter the demand for their products. Consumption of beer, wine, and liquor is declining; so is the traditional high-volume category of sugar-sweetened carbonated beverages, with consumers shifting toward lower-calorie options, flavored bottled water, and functional beverages. While the types of microbiology tests conducted will remain stable (albeit with a few noticeable shifts), the customer base for diagnostic test and supply companies will be shifting to these smaller beverage companies—at least, until they are acquired by the large multinationals that dominate the beverage industry.
In the meantime, the beverage sector will see steady test volume growth in the low single-digit range. Most of the testing in beverage focuses on indicator and water quality tests, with few product categories requiring tests for pathogens. This sector has not seen a conversion to higher-priced, instrument-based tests; most testing is conducted using traditional growth methods or the prepared "convenience" formats of those same growth methods. This stability means that the beverage sector has not seen an impact on pricing from the format shift seen in the food sector. It also means that this sector has not witnessed the impact of the hyper-competitive market seen for those tests. Pricing has been more stable and, in many cases, is growing modestly. This has led to moderate growth in market value and ACT in the beverage sector, with both forecast to grow at a few points faster than the market volume growth.
Conclusion
While competitors in the food safety and beverage microbiology testing markets will face market challenges that they have not faced before, the market will continue to produce steady growth through the end of this decade. This market will offer expanding opportunities for those companies that can innovate and effectively compete in a modestly growing, increasingly global, highly competitive market. The environment of price competition, customer consolidation and outsourcing, and increasing perception of risk by the public will drive a more complicated regulatory landscape.
To find out more, download the summary and prospectus of Strategic Consulting Inc.'s IMMR-6 report here.
References
- Ferguson, B. "Food Safety Markets and Trends—Developments to Watch." Food Safety Magazine August/September 2025. https://www.food-safety.com/articles/10606-food-safety-markets-and-trendsdevelopments-to-watch.
Bob Ferguson is President of Strategic Consulting Inc. and can be reached at bobferguson9806@gmail.com or on X/Twitter at @SCI_Ferguson.